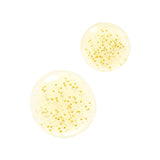

Agotado
New
GUERLAIN Abeille Royale Youth Watery Oil Serum 30ml NIB
Subcribe to back in stock notification
Buy 2 or more beauty items and receive 10% off each item!
ALL beauty items carried at LAB Luxury Resale are unused. Some may not come in original packaging. We try our hardest to include packaging information in all of our listings. Alas we are humans and make errors from time to time. If you have any questions prior to purchasing, please ask us!
What it is: The new-generation Serum with its light texture designed for all skin types provides deep repair of aging signs from the first drops¹.
Skin Type: Normal, Dry, Combination, and Oily
Skincare Concerns: Dullness, Fine Lines and Wrinkles, and Loss of Firmness and Elasticity
Formulation: Serum
Highlighted Ingredients:
- Trogstad Honey, Norway: Revitalizes skin and corrects visible signs of aging.
- Ouessant Honey, France: Supports skin youth repair with an abundance of amino acids.
- Connemara Honey, Ireland: Visibly reduces fine lines and wrinkles.
Ingredient Callouts: Free of parabens, formaldehydes, formaldehyde-releasing agents, phthalates, mineral oil, retinyl palmitate, oxybenzone, coal tar, hydroquinone, sulfates SLS & SLES, triclocarban, and triclosan. It is also gluten-free.
What Else You Need to Know: Developed by Guerlain laboratories, this oil features a unique texture that penetrates deeply into the skin's layers, delivering powerful age-defying benefits from the first drop. Perfumed with a sun-drenched nectar by Thierry Wasser, it reveals fresh, light, and honeyed notes.
Clinical Results:
New clinically proven performance: immediate and long-lasting efficacy.
AFTER THE 1st DROPS: deep repair of aging signs
Strengthened barrier
AFTER 1 HOUR: The skin is visibly plumped with youth
-25% wrinkles ²
+124% hydration³
AFTER 1 MONTH: The signs of aging are visibly corrected, the panel found their skin⁴:
smoother
firmer
more elastic